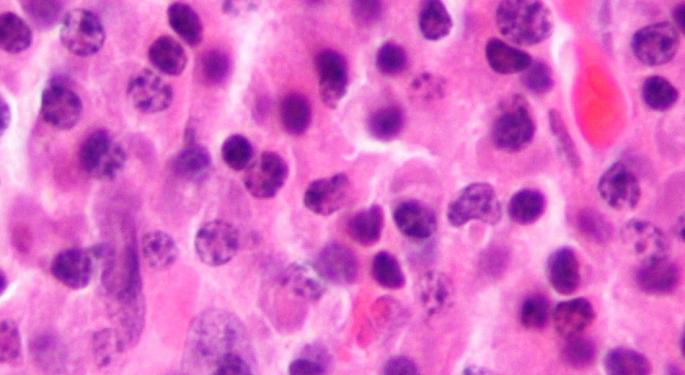

2016-2022 All Rights Reserved.平安財經網.復制必究 聯系QQ 備案號:
本站除標明“本站原創”外所有信息均轉載自互聯網 版權歸原作者所有。
郵箱:toplearningteam#gmail.com (請將#換成@)
FDA延遲Selinexor批準3個月 - 那么為什么Karyopharm撕裂更高?
KPTI 0.42%股票在FDA發布的簡報文件及其多發性骨髓瘤治療候選人Selinexor的專題投票結果后于2月底遭遇挫折,其股價周五上漲勢頭增加了一倍。
發生了什么
Karyopharm周四表示,在4月6日至7月6日的原始PDUFA日期之前,FDA已將Selinexor的NDA與地塞米松聯合使用的審核期延長三個月。
正在評估Selinexor組合治療復發難治性多發性骨髓瘤患者,這些患者至少接受過三次治療。
Karyopharm將延遲歸咎于FDA要求增加 - 但已經存在 - 作為Adcom會議后NDA修正案的信息。
“我們期待與FDA繼續合作,努力滿足復發難治性多發性骨髓瘤患者的需求,”Karyopharm的創始人,總裁兼首席科學官Sharon Shacham在一份聲明中說。
為什么這很重要
在FDA簡報文件可供2月22日通過了FDA的腫瘤藥物咨詢委員會審查,并表達了對安全性和有效性表示擔心。
在2月26日的會議之后,FDA小組以8-5投票贊成推遲Selinexor的批準,直到第3階段BOSTON試驗結果公布為止。波士頓的試驗讀數預計至少要到2019年末或2020年。
盡管批準延遲,但積極的股票反應可能是由于Karyopharm可能不需要進行進一步的臨床試驗以滿足監管機構的要求。
美國食品和藥物管理局(FDA)傳達的三個月延遲提出了一個微弱的希望,即在Adcom會議之后的預期時間之前得到批準。
雖然提供的其他臨床信息的確切性質尚不清楚,但FDA的行動令人鼓舞,特別是因為該機構以前只需要2b階段STORM研究的結果,Wedbush分析師David Nierengarten在周五的一份報告中說。
“盡管如此,雖然這一發展可能對KPTI有利,但在波士頓現在是一個更高概率事件(但仍然明顯存在問題)之前獲得批準,我們維持我們的估計和估值,直到進一步更新,”該分析師表示。
下一步是什么
現在重點轉移到7月6日的PDUFA日期,屆時將確定Selinexor是否足以清除FDA的障礙。
HC Wainwright分析師愛德華·懷特(Edward White)引用新的PDUFA日期表示,他將推遲對Selinexor的發布預期三個月,從而將目標價格從30美元降至29美元。該公司維持對Karyopharm的買入評級。
盡管周五出現反彈,但Karyopharm的股票仍然不在他們的預發布文件發布水平,大約9美元。
最后一次檢查,股價上漲10.68%至4.87美元。
相關鏈接:
每日生物技術脈沖:KaryoPharm的Selinexor評論延遲
2016-2022 All Rights Reserved.平安財經網.復制必究 聯系QQ 備案號:
本站除標明“本站原創”外所有信息均轉載自互聯網 版權歸原作者所有。
郵箱:toplearningteam#gmail.com (請將#換成@)